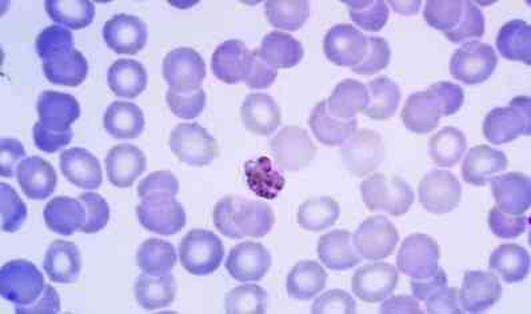
Sivrisineklerdeki gizli tehlike! Sıtma nedir ve neden olur?

Sivrisineklerdeki gizli tehlike! Sıtma nedir ve neden olur?

Sivrisinekler, sıtma hastalığının yayılmasında önemli bir rol oynayan vektörlerdir. Ancak, sıtma hastalığına neden olan parazit, Plasmodium adı verilen protozoanlar tarafından taşınır ve insanlara sivrisineklerin ısırması yoluyla bulaşır. Bunlar, sıtma parazitlerini taşıyan dişi Anopheles cinsi sivrisineklerdir. Sıtma nedir ve neden olur, belirtileri neler, sıtma olan kişi ne yapmalı muhakkak bilinmelidir.
Sıtma, özellikle tropikal ve subtropikal bölgelerde, sivrisineklerin daha yoğun olduğu alanlarda yaygın olarak görülür. Ciddi sağlık sorunlarına yol açabilen bir hastalıktır ve dünya çapında milyonlarca insanı etkilemektedir. Sıtmanın önlenmesi ve kontrolü ise sivrisinek ısırıklarından korunma ve sıtma tedavisinin erken teşhisi ve etkili tedavisi gibi stratejilere dayanmaktadır. Peki sıtma nedir ve neden olur, belirtileri neler, sıtma olan kişi ne yapmalı?
SITMA NEDİR VE NEDEN OLUR?
Sıtma, Plasmodium adı verilen parazitlerin neden olduğu bir enfeksiyöz hastalıktır. Bu parazitler, insanlarla sivrisinekler arasında bulaşır ve hastalığın yayılmasına neden olur. Sıtma, özellikle tropikal ve subtropikal bölgelerde yaygın olarak görülür. Genellikle dişi Anopheles cinsi sivrisinekler tarafından insanlara ısırıldıktan sonra bulaşır. Sivrisineklerin kanlarında bulunan sıtma parazitleri, insan kan dolaşımına girer ve burada çoğalır. Plasmodium parazitleri insan vücudunda karaciğer ve kırmızı kan hücrelerinde yaşarlar.
Sıtma, Plasmodium falciparum, Plasmodium vivax, Plasmodium ovale ve Plasmodium malariae gibi çeşitli Plasmodium türleri tarafından oluşabilir. En yaygın ve en ciddi türlerden biri Plasmodium falciparum'dur, çünkü bu tür sık sık ciddi komplikasyonlara neden olabilir ve ölümcül olabilir.
Sıtma, önlenmesi ve kontrolü zor bir hastalıktır, ancak sıtmanın önlenmesi ve tedavisi için çeşitli stratejiler bulunmaktadır. Bu stratejiler arasında sivrisinek ısırıklarından korunma, sıtma tedavisinin erken teşhisi ve etkili tedavisi, sıtma aşıları ve sivrisinek popülasyonlarının kontrolü yer alır.

SITMA BELİRTİLERİ NELER?
Sıtma, semptomlarının şiddeti ve türüne bağlı olarak değişebilen bir hastalıktır. Bazı sıtma enfeksiyonları hafif semptomlarla seyrederken, diğerleri ciddi komplikasyonlara yol açabilir. Genel olarak, sıtmanın yaygın belirtileri şunlardır:
Yüksek Ateş
Titreme
Terleme
Baş Ağrısı
Kas Ağrıları
Halsizlik ve Yorgunluk
Sıtma semptomları, enfeksiyonun şiddeti, parazitin türü ve hastanın bağışıklık durumu gibi faktörlere bağlı olarak değişebilir. Bazı sıtma enfeksiyonları hafif semptomlarla seyrederken, diğerleri ciddi komplikasyonlara yol açabilir. Ayrıca, sıtma belirtileri grip veya başka enfeksiyonlarla benzerlik gösterebilir, bu nedenle doğru teşhis ve tedavi için tıbbi yardım almak önemlidir.
Sıtma mikrobu
Sıtma mikrobu
SITMA TEDAVİSİ NASIL YAPILIR?
Sıtma tedavisi, hastalığın nedeni olan Plasmodium parazitlerinin vücuttan temizlenmesini ve semptomların iyileştirilmesini amaçlar. Sıtma tedavisi, enfeksiyonun şiddeti, parazitin türü, hastanın yaşı ve sağlık durumu gibi faktörlere bağlı olarak değişiklik gösterebilir. İşte sıtma tedavisinde kullanılan bazı yaygın yöntemler:
Antimalaryal İlaçlar: Sıtma tedavisinde genellikle antimalaryal ilaçlar kullanılır. Bu ilaçlar, sıtma parazitlerini öldürerek enfeksiyonu tedavi etmeye yardımcı olur. Antimalaryal ilaçların kullanımı, hastanın yaşı, ağırlığı, sıtma türü ve diğer faktörlere bağlı olarak değişebilir. Tedavi süresi ve ilaç dozu, enfeksiyonun şiddetine ve parazitin direncine bağlı olarak belirlenir.
Kombinasyon Tedavisi: Bazı durumlarda, sıtma tedavisi için birden fazla antimalaryal ilacın kombinasyonu kullanılabilir. Bu yaklaşım, farklı ilaçların farklı etki mekanizmalarını hedefleyerek enfeksiyonu daha etkili bir şekilde tedavi etmeyi amaçlar.
Semptomatik Tedavi: Sıtma semptomlarını hafifletmek için semptomatik tedavi uygulanabilir. Ağrı kesiciler, ateş düşürücü ilaçlar, antiemetikler (kusmayı önleyici ilaçlar) ve hidrasyon tedavisi gibi semptomlara yönelik tedaviler kullanılabilir.
Yatak İstirahati: Sıtma tedavisi sırasında dinlenmek ve yatak istirahati önemlidir. Dinlenme, vücudun enfeksiyonla mücadelesine ve iyileşmesine yardımcı olabilir.
Sıtma Komplikasyonlarının Tedavisi: Bazı sıtma enfeksiyonları ciddi komplikasyonlara yol açabilir. Örneğin, Plasmodium falciparum türü sıtma ciddi komplikasyonlara neden olabilir, bu nedenle hastaların yoğun bakım ve diğer tıbbi müdahalelere ihtiyacı olabilir.















